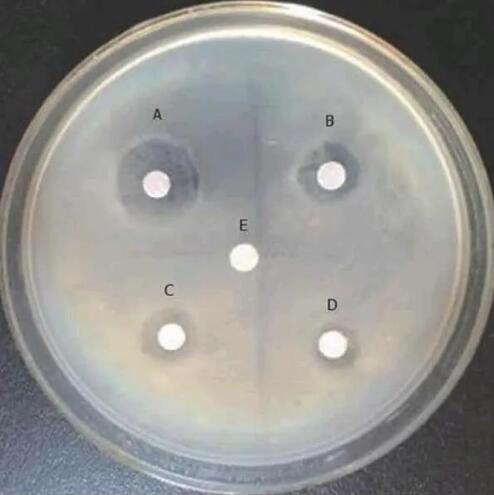

技術(shù)服務(wù)HUA CHEN
您當(dāng)前的位置:首頁 >> 技術(shù)服務(wù)
新技術(shù)可能會對抗生素的使用、耐藥性產(chǎn)生新的見解
最低抑菌濃度(MIC)是測定抗生素耐藥性的常用工具。Noyes表示,由于使用了一段時間,它可以提供一些歷史數(shù)據(jù),研究人員和獸醫(yī)可以輕松解釋。
“MIC的價值來自于一種基于文化的耐藥性監(jiān)測方法,”她解釋道?!爱?dāng)我們進(jìn)行培養(yǎng)時,我們必須‘挑選’目標(biāo)細(xì)菌,比如沙門氏菌或大腸桿菌,或者可能是另一種動物病原菌。我們必須專門培養(yǎng)這種病原體,并確定它是否能夠抵抗抗生素或者對抗生素敏感?!?/span>
知道這一點很重要,但這也意味著宿主體內(nèi)可能發(fā)生了很多其他無法定量的事情。
她說,“我們知道我們的世界和我們的身體居住著數(shù)百萬種不同的細(xì)菌。我們甚至還不知道它們中的大多數(shù)是什么,但它們都可能會產(chǎn)生耐藥性?!?/span>
Noyes說:“當(dāng)我們用MIC測試數(shù)千種不同類型的細(xì)菌中很小一種細(xì)菌時,我們可能并沒有得到一個非常具有代表性的關(guān)于整個種群的抗藥性動態(tài)。為了真正對抗耐藥性,我們需要了解整個微生物種群在做什么,而不僅僅是對我們感興趣的細(xì)菌?!?/span>
這是新技術(shù)發(fā)揮作用的地方,盡管存在學(xué)習(xí)上的困難。Noyes說,由于對新技術(shù)的熟悉程度較低,因此需要花費時間來了解特定的數(shù)據(jù)對人類或動物健康的含義。但是,從積極的方面來說,它們的應(yīng)用范圍更廣,對抗生素耐藥性的總體了解更好。

新的測試基本上是一種測序技術(shù),現(xiàn)在變得越來越容易使用。Noyes對他們的潛力感到興奮。
她說:“我們現(xiàn)在可以對樣品中的所有細(xì)菌進(jìn)行測序。這些儀器功能強(qiáng)大,可以為我們提供大量數(shù)據(jù)。我們可以取樣,而不是專注于特定的細(xì)菌,而是對所有DNA進(jìn)行測序。然后,我們可以將DNA與已知的序列進(jìn)行比較。如果找到匹配項,我們可以說:‘好吧,這是細(xì)菌X,這是耐藥基因A’。借助這項技術(shù),我們可以了解整個微生物種群?!?/span>
她說,這種“深度測序”提供了一個動物整體微生物種群的狀況。它甚至可以捕獲罕見的細(xì)菌,盡管她承認(rèn)在樣本中收集的一些信息還沒有完全弄明白。這項新技術(shù)讓研究人員可以更深入地了解動物和動物種群的變化。

通過新的測試,研究人員可以查看存在哪些細(xì)菌以及存在哪些耐藥基因。
Noyes說:“以沙門氏菌為例,‘這種特定的沙門氏菌具有三個耐藥基因,’我們在一個樣本中發(fā)現(xiàn)了數(shù)百甚至有時數(shù)千種不同的耐藥基因?!?/span>
她補充說:“細(xì)菌對不同的化合物具有天然的耐藥性,這是它們在面對不同挑戰(zhàn)時得以生存的一種本能?!?/span>
她指出,即使在原始環(huán)境中,比如無人居住的島嶼或北極,研究人員也在細(xì)菌中發(fā)現(xiàn)了耐藥基因,盡管它們從未接觸過現(xiàn)代抗生素。
Noyes說:“這項技術(shù)讓我們對抗藥性有了更全面的了解,也讓我們知道這是一種自然現(xiàn)象。困難在于分析和解釋數(shù)據(jù),以及理解我們對這些測量的敏感度?!?/span>

這項新技術(shù)讓研究人員更廣泛地了解農(nóng)場層面的決策如何影響動物,從而更深入地了解健康干預(yù)措施。
Noyes解釋說,只要有人管理群體,無論是人類、動物還是環(huán)境,這些種群都會受到微生物的影響。
她說:“我們沒有認(rèn)真考慮這個問題,因為它們是微小的,但我們正在改變它們的生態(tài)。因此,我們學(xué)到的不僅僅是抗菌藥物的使用;這關(guān)系到整個畜牧生產(chǎn)系統(tǒng)。”
Noyes認(rèn)為,豬獸醫(yī)界在與抗生素使用相關(guān)的管理工作方面做得非常出色,但需要繼續(xù)圍繞該管理工作提供證據(jù)。
她說:“我們需要證明,我們所做的確實是在發(fā)揮作用?!痹撔袠I(yè)如何使用抗生素抗擊疾病以及耐藥性,是證明這些做法正在產(chǎn)生積極影響的證據(jù)基礎(chǔ)的一部分。


Noyes說,她對抗生素耐藥性的看法與學(xué)生時代有所不同。她曾經(jīng)認(rèn)為抗生素耐藥性更多是一種線性現(xiàn)象:用藥后就會產(chǎn)生抗藥性。她最大的驚喜之一是了解到抗生素耐藥性問題是多么復(fù)雜,以及預(yù)測抗菌素耐藥性何時會成為一個問題是多么具有挑戰(zhàn)性。
她也認(rèn)識到抗生素耐藥性并不是一個非黑即白的問題。她希望該行業(yè)能繼續(xù)積累證據(jù),幫助人們了解,生產(chǎn)者的許多做法對提高動物健康和福利至關(guān)重要。
Noyes說,“從動物福利和耐藥性的角度來看,替代療法可能是有害的?!?/span>
Noyes說,提供關(guān)于抗生素預(yù)防性用藥的成本效益的信息將為關(guān)于抗生素使用的循證討論奠定基礎(chǔ),它對動物健康和福利意味著什么,以及它在耐藥性方面意味著什么,需要進(jìn)一步的觀察與研究。
注:本文章來源于技術(shù)部。歡迎咨詢參考。
下一篇:冬季帶豬消毒的問題





